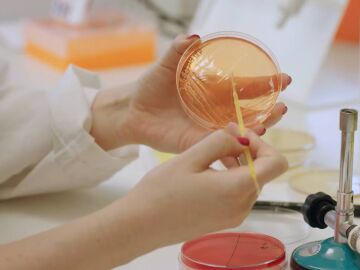
Microbioma

Astronomía, divulgación, descubrimientos, ecología, innovación...

Un científico español crea vida sintética capaz de imitar a sistemas orgánicos

El cráneo de estegosaurio más completo de Europa aparece en Teruel

Descubren en Segovia la huella dactilar más antigua del mundo

Una moda más sostenible: en vez de tintes, nanoestructuras que manipulen el color

Identifican el gen FOXP4 que puede estar relacionado con la persistencia de la covid

Nuevas lentillas infrarrojas permiten ver en la oscuridad

Aurora, la IA que puede revolucionar las predicciones meteorológicas

"Códigos de barras" en el ADN revelan cómo envejece la sangre